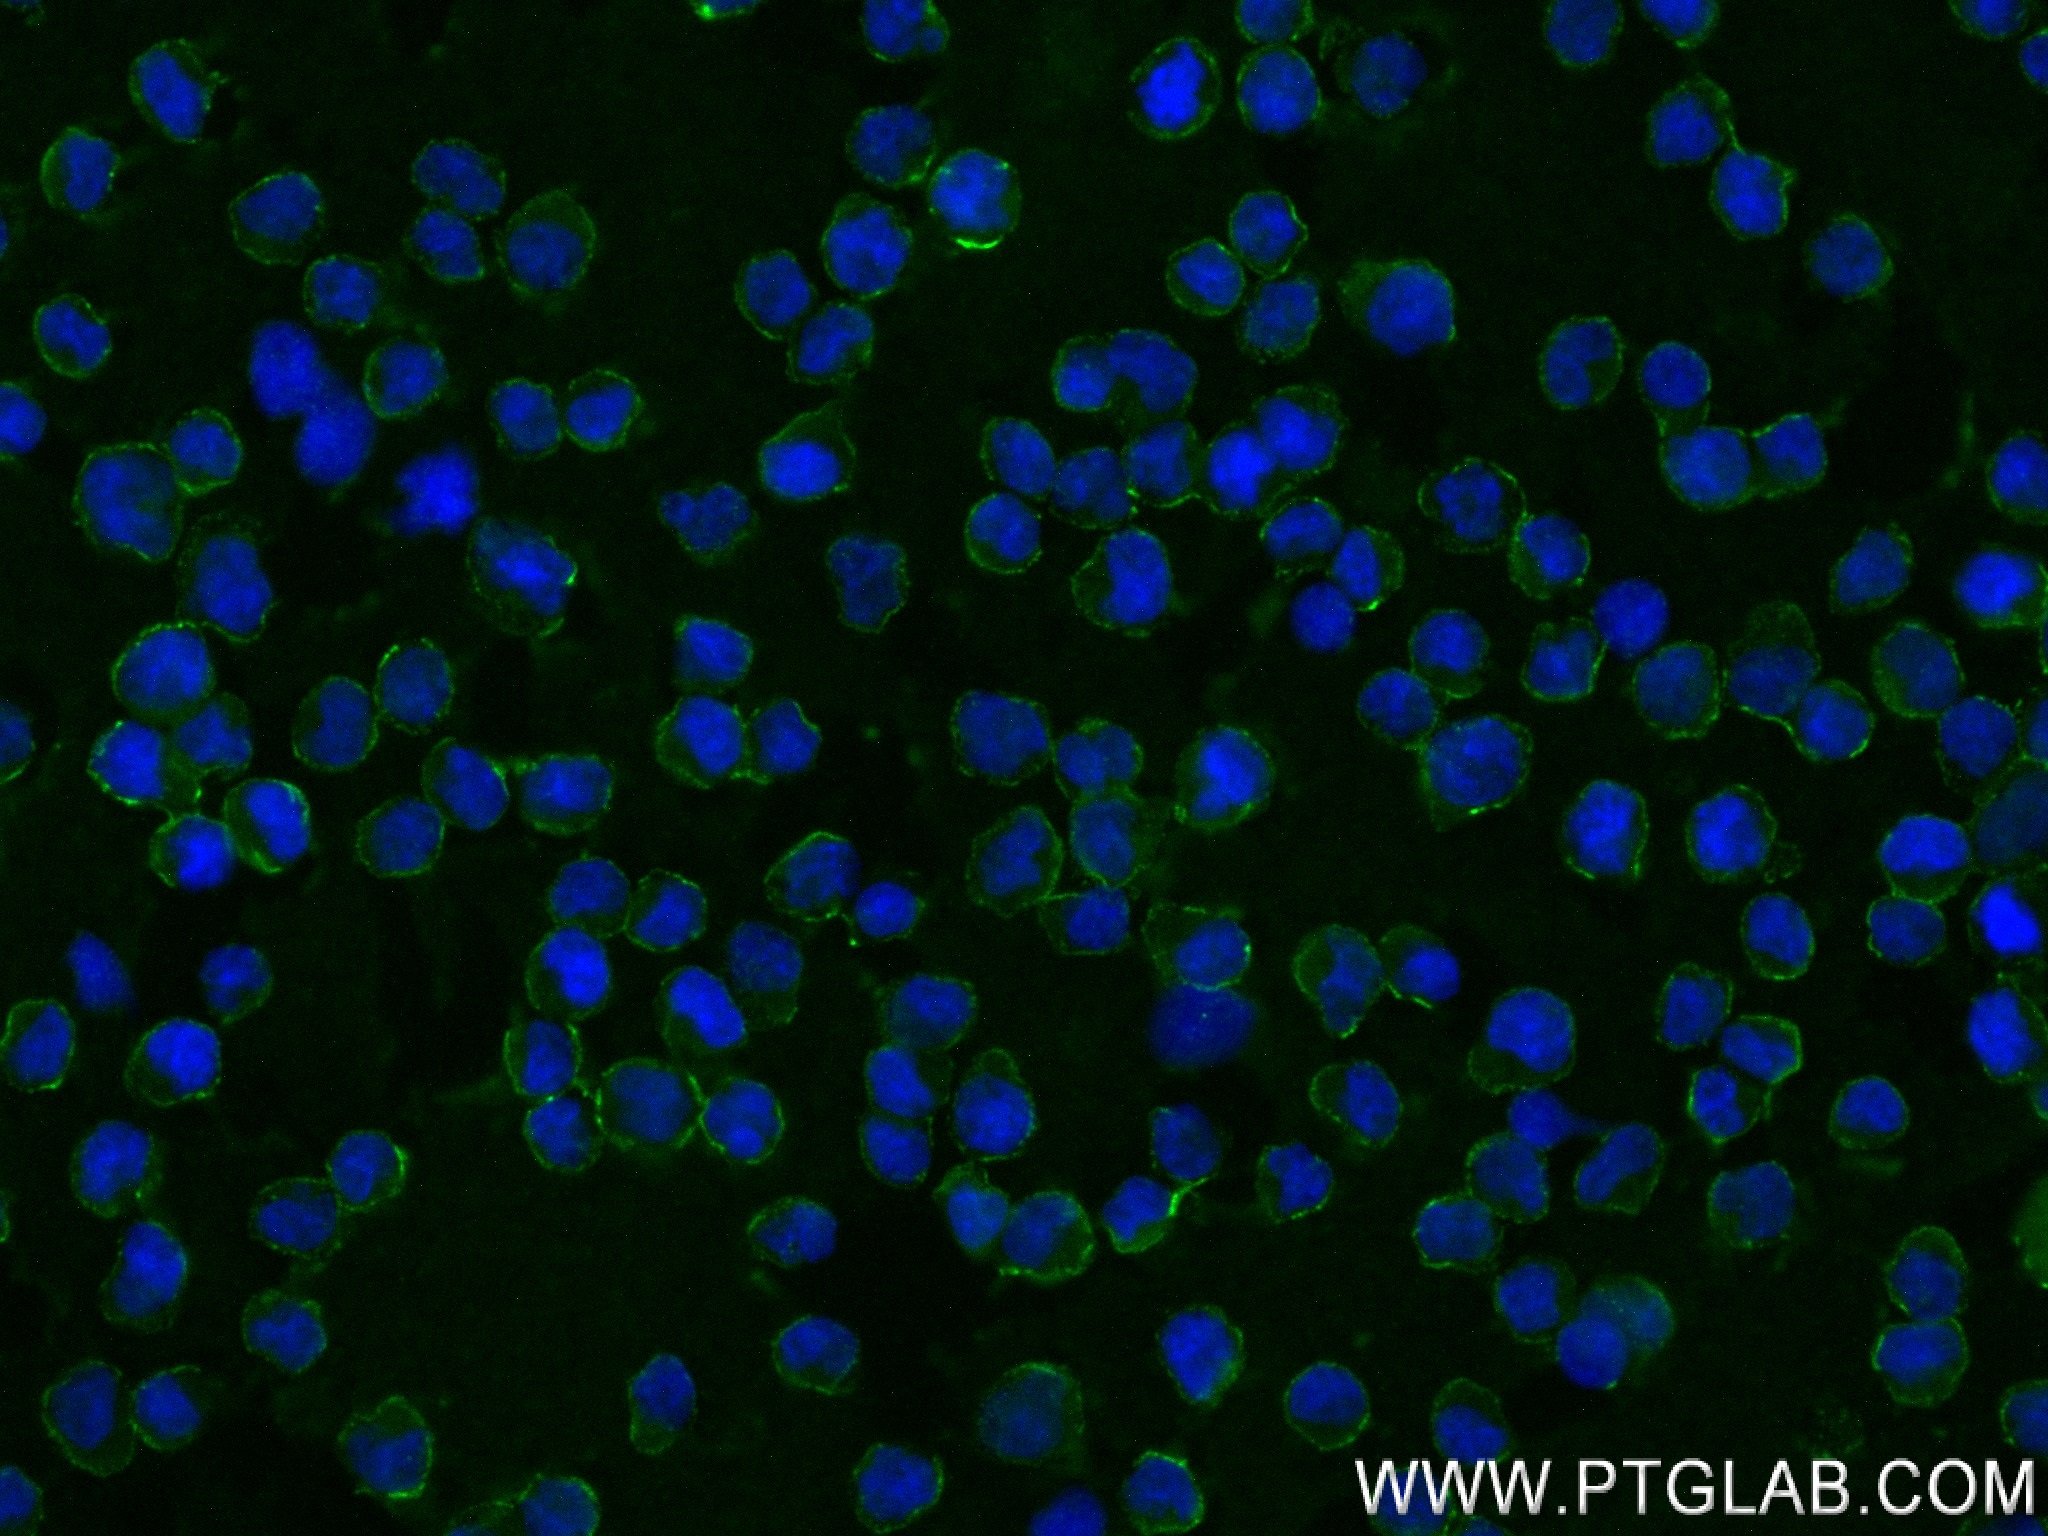

验证数据展示
产品信息
82747-2-PBS targets CD79a in IF/ICC, IF-P, Indirect ELISA applications and shows reactivity with human samples.
| 经测试应用 | IF/ICC, IF-P, Indirect ELISA Application Description |
| 经测试反应性 | human |
| 免疫原 |
CatNo: Ag17924 Product name: Recombinant human CD79A protein Source: e coli.-derived, PGEX-4T Tag: GST Domain: 33-144 aa of BC113733 Sequence: LWMHKVPASLMVSLGEDAHFQCPHNSSNNANVTWWRVLHGNYTWPPEFLGPGEDPNGTLIIQNVNKSHGGIYVCRVQEGNESYQQSCGTYLRVRQPPPRPFLDMGEGTKNRI 种属同源性预测 |
| 宿主/亚型 | Rabbit / IgG |
| 抗体类别 | Recombinant |
| 产品类型 | Antibody |
| 全称 | CD79a molecule, immunoglobulin-associated alpha |
| 别名 | 1I17, B-cell antigen receptor complex-associated protein alpha chain, MB 1, MB 1 membrane glycoprotein, MB1 |
| 计算分子量 | 226 aa, 25 kDa |
| GenBank蛋白编号 | BC113733 |
| 基因名称 | CD79A |
| Gene ID (NCBI) | 973 |
| 偶联类型 | Unconjugated |
| 形式 | Liquid |
| 纯化方式 | Protein A purification |
| UNIPROT ID | P11912 |
| 储存缓冲液 | PBS only, pH 7.3. |
| 储存条件 | Store at -80°C. The product is shipped with ice packs. Upon receipt, store it immediately at -80°C |
背景介绍
CD79a, also named as B-cell antigen receptor complex-associated protein alpha chain or MB-1 membrane glycoprotein, is a 226 amino acid protein, which contains one ITAM domain and one Ig-like C2-type (immunoglobulin-like) domain. CD79A is expressed in B cells and localizes in the cell membrane. CD79A is required in cooperation with CD79B for initiation of the signal transduction cascade activated by binding of antigen to the B-cell antigen receptor complex (BCR) which leads to internalization of the complex, trafficking to late endosomes and antigen presentation. CD79A is also required for BCR surface expression and for efficient differentiation of pro- and pre-B-cells.